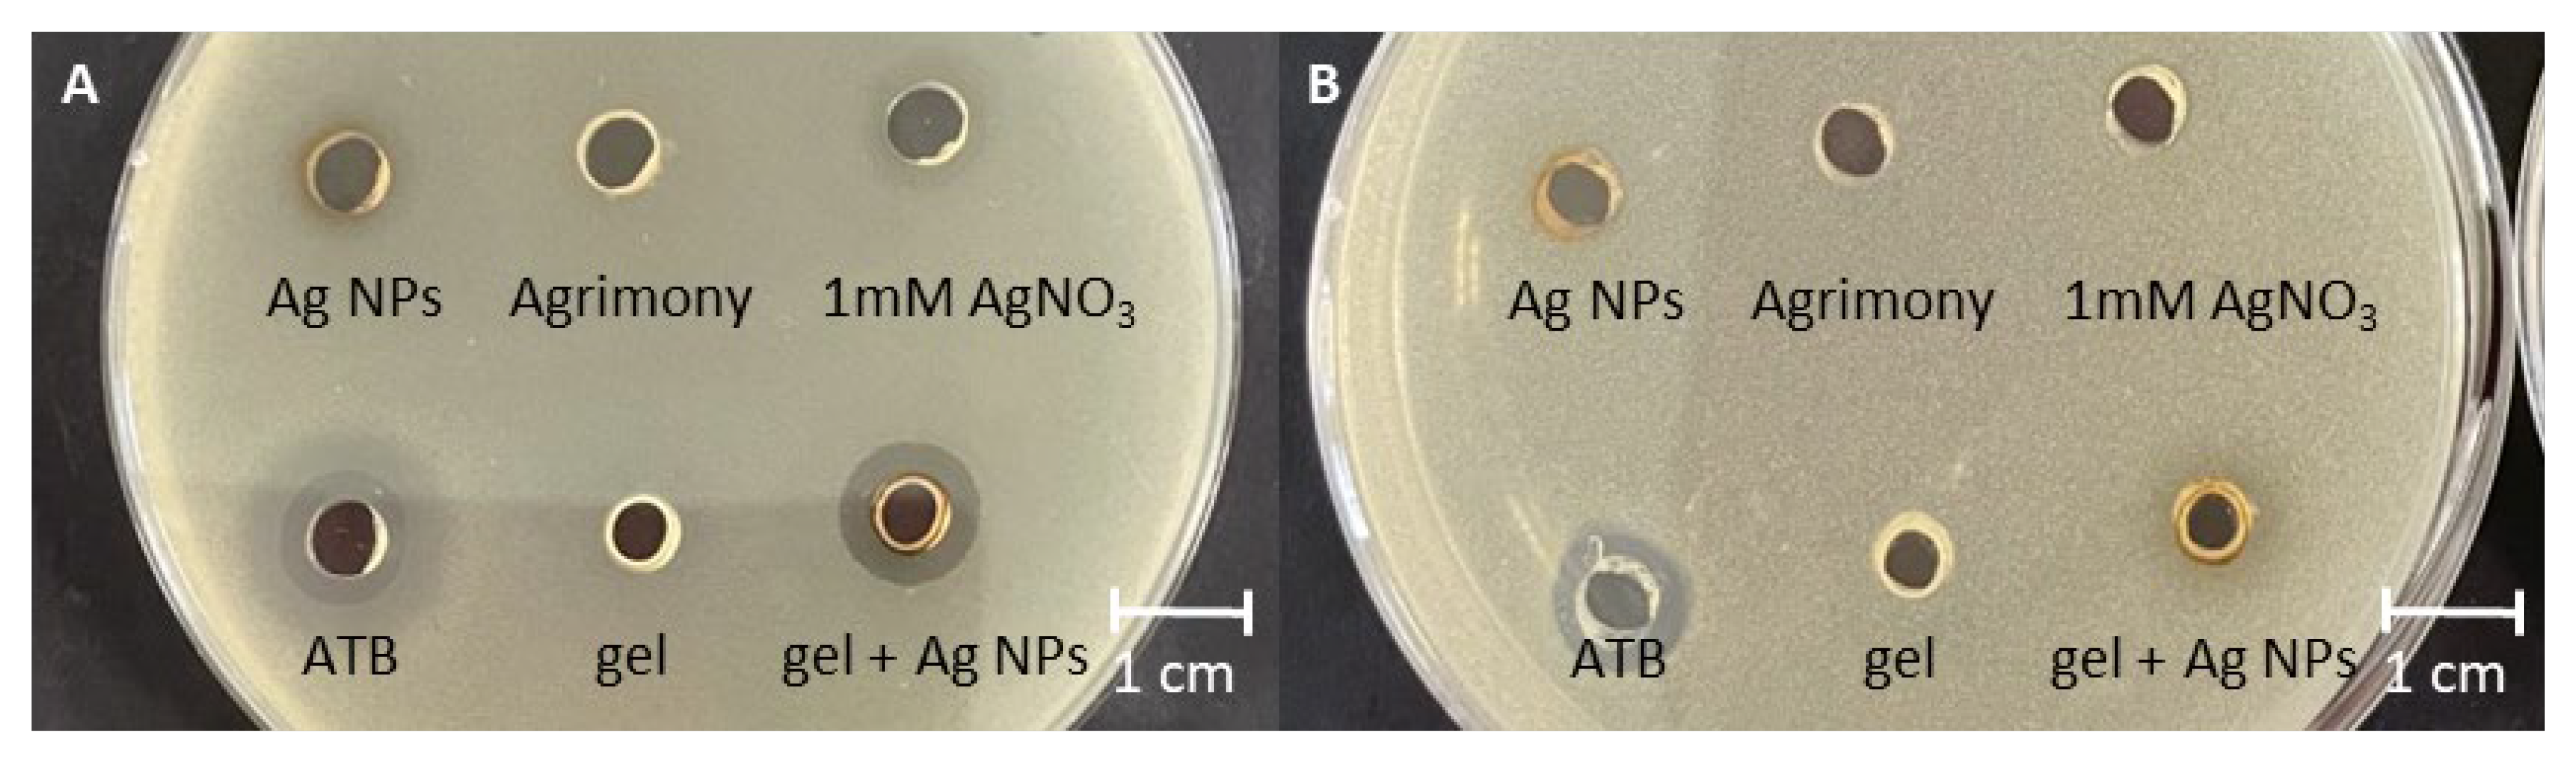
Life 13 00573 g007

In Situ Gel with Silver Nanoparticles Prepared Using Agrimonia eupatoria L. Shows Antibacterial Activity
Abstract
1. Introduction
2. Materials and Methods
2.1. Chermicals
2.2. Plant Material Preparation and Characterization
2.2.1. Phytochemical Characterization
2.2.2. HPLC Analysis
2.3. Green Synthesis of Silver Nanoparticles
2.4. Characterization of Silver Nanoparticles
2.4.1. Spectrophotometric Analysis
2.4.2. Transmission Electron Microscopy
2.4.3. Fourier Transform Infrared Spectroscopy (FTIR)
2.4.4. Size Distribution
2.4.5. Zeta Potential
2.5. Preparation of Sols
2.6. Preparation of Sols Loaded with Nanoparticles
2.7. Stability of Nanoparticles and In Situ Gels Loaded with Ag NPs
2.8. Antibacterial Activity
2.9. Statistical Analysis
3. Results and Discussion
3.1. Phytochemical Characterization
3.2. Green Synthesis
3.3. Characterization of Nanoparticles
3.3.1. Transmission Electron Microscopy

3.3.2. FTIR Analysis
3.4. Preparation of In Situ Gel
3.5. Stability of Ag NPs and Ag NPs in Gel
3.5.1. Size Distribution
3.5.2. Zeta Potential
3.5.3. Spectroscopic Analysis
3.6. Antibacterial Activity
4. Conclusions
Author Contributions
Funding
Institutional Review Board Statement
Informed Consent Statement
Data Availability Statement
Conflicts of Interest
References
- Cui, H.; You, Y.; Cheng, G.W.; Lan, Z.; Zou, K.L.; Mai, Q.Y.; Han, Y.H.; Chen, H.; Zhao, Y.Y.; Yu, G.T. Advanced materials and technologies for oral diseases. Sci. Technol. Adv. Mater. 2023, 24, 1. [Google Scholar] [CrossRef] [PubMed]
- Sastri, T.K.; Gupta, V.N.; Chakraborty, S.; Madhusudhan, S.; Kumar, H.; Chand, P.; Jain, V.; Veeranna, B.; Gowda, D.V. Novel Gels: An Emerging Approach for Delivering of Therapeutic Molecules and Recent Trends. Gels 2022, 8, 316. [Google Scholar] [CrossRef] [PubMed]
- Nguyen, Q.V.; Huynh, D.P.; Park, J.H.; Lee, D.S. Injectable polymeric hydrogels for the delivery of therapeutic agents: A review. Eur. Polym. J. 2015, 72, 602–619. [Google Scholar] [CrossRef]
- Zahir-Jouzdani, F.; Wolf, J.D.; Atyabi, F.; Bernkop-Schnurch, A. In situ gelling and mucoadhesive polymers: Why do they need each other? Expert Opin. Drug Deliv. 2018, 15, 1007–1019. [Google Scholar] [CrossRef]
- Baláž, M.; Daneu, N.; Balážová, Ľ.; Dutková, E.; Tkáčiková, Ľ.; Briančin, J.; Vargová, M.; Balážová, M.; Zorkovská, A.; Baláž, P. Bio-mechanochemical synthesis of silver nanoparticles with antibacterial activity. Adv. Powder Technol. 2017, 28, 3307–3312. [Google Scholar] [CrossRef]
- Shalabayev, Z.; Baláž, M.; Daneu, N.; Dutková, E.; Bujňáková, Z.; Kaňuchová, M.; Danková, Z.; Balážová, Ľ.; Urakaev, F.; Tkáčiková, L.; et al. Sulfur-Mediated Mechanochemical Synthesis of Spherical and Needle-like Copper Sulfide Nanocrystals with Antibacterial Activity. ACS Sustain. Chem. Eng. 2019, 7, 12897–12909. [Google Scholar] [CrossRef]
- Baláž, M.; Balážová, Ľ.; Daneu, N.; Dutková, E.; Balážová, M.; Bujňáková, Z.; Shpotyuk, Y. Plant-mediated synthesis of silver nanoparticles and their stabilization by wet stirred media milling. Nanoscale Res. Lett. 2017, 12, 1–9. [Google Scholar] [CrossRef]
- Kharissova, O.V.; Dias, H.V.R.; Kharisov, B.I.; Perez, B.O.; Perez, V.M.J. The greener synthesis of nanoparticles. Trends Biotechnol. 2013, 31, 240–248. [Google Scholar] [CrossRef]
- Akyuz, G.; Kaymazlar, E.; Ay, H.; Andac, M.; Andac, O. Use of Silver Nanoparticles Loaded Locust Bean Gum Coatings to Extend the Shelf-Life of Fruits. Biointerface Res. Appl. Chem. 2023, 13, 3. [Google Scholar]
- Saravanan, M.; Arokiyaraj, S.; Lakshmi, T.; Pugazhendhi, A. Synthesis of silver nanoparticles from Phenerochaete chrysosporium (MTCC-787) and their antibacterial activity against human pathogenic bacteria. Microb. Pathog. 2018, 117, 68–72. [Google Scholar] [CrossRef]
- Saravanan, M.; Barik, S.K.; MubarakAli, D.; Prakash, P.; Pugazhendhi, A. Synthesis of silver nanoparticles from Bacillus brevis (NCIM 2533) and their antibacterial activity against pathogenic bacteria. Microb. Pathog. 2018, 116, 221–226. [Google Scholar] [CrossRef]
- Iqbal, S.; Khan, F.A.; Haris, A.; Mozuraitis, R.; Binyameen, M.; Azeem, M. Essential oils of four wild plants inhibit the blood seeking behaviour of female Aedes aegytpi. Exp. Parasitol. 2023, 244, 108424. [Google Scholar] [CrossRef]
- Malheiros, J.; Simoes, D.M.; Figueirinha, A.; Cotrim, M.D.; Fonseca, D.A. Agrimonia eupatoria L.: An integrative perspective on ethnomedicinal use, phenolic composition and pharmacological activity. J. Ethnopharmacol. 2022, 296, 115498. [Google Scholar] [CrossRef]
- Santos, T.N.; Costa, G.; Ferreira, J.P.; Liberal, J.; Francisco, V.; Paranhos, A.; Cruz, M.T.; Castelo-Branco, M.; Figueiredo, I.V.; Batista, M.T. Antioxidant, Anti-Inflammatory, and Analgesic Activities of Agrimonia eupatoria L. Infusion. Evid.-Based Complement. Altern. Med. 2017, 2017, 8309894. [Google Scholar] [CrossRef]
- Paluch, Z.; Biriczova, L.; Pallag, G.; Marques, E.C.; Vargova, N.; Kmonickova, E. The Therapeutic Effects of Agrimonia eupatoria L. Physiol. Res. 2020, 69, S555–S571. [Google Scholar] [CrossRef]
- Singleton, V.L.; Rossi, J.A. Colorimetry of total phenolics with phosphomolybdic-phosphotungstic acid reagents. Am. J. Enol. Vitic. 1965, 3, 144–158. [Google Scholar]
- Lamaison, J.L.; Carnat, A. Levels of principal flavonoids in flowers and leaves of Crataegus monogyna Jacq and Crataegus laevigata (Poiret) dc (Rosaceae). Pharm. Acta Helv. 1990, 65, 315–320. [Google Scholar]
- The Polish Farmaceutical Society. Farmakopea Polska V; Polskie Towarzystwo Farmaceutyczne: Warsaw, Poland, 1999; Volume 5. [Google Scholar]
- Sadeer, N.B.; Montesano, D.; Albrizio, S.; Zengin, G.; Mahomoodally, M.F. The Versatility of Antioxidant Assays in Food Science and Safety-Chemistry, Applications, Strengths, and Limitations. Antioxidants 2020, 9, 709. [Google Scholar] [CrossRef]
- Schmolka, I.R. Artificial skin. 1. Preparation and properties of pluronic F-127 gels for treatment of burns. J. Biomed. Mater. Res. 1972, 6, 571–582. [Google Scholar] [CrossRef]
- Rojas, J.J.; Ochoa, V.J.; Ocampo, S.A.; Muñoz, J.F. Screening for antimicrobial activity of ten medicinal plants used in Colombian folkloric medicine: A possible alternative in the treatment of non-nosocomial infections. BMC Complement. Altern. Med. 2006, 6, 1–6. [Google Scholar] [CrossRef]
- Tomiq, V.; Eftimová, J.; Petrovič, V. Influence of different extraction agents on the total polyphenol content, antioxidant activity and toxicity of Agrimonia eupatoria L. extracts. Folia Pharm. Cassoviensia 2022, 4, 62–73. [Google Scholar]
- Granica, S.; Krupa, K.; Klebowska, A.; Kiss, A.K. Development and validation of HPLC-DAD-CAD-MS3 method for qualitative and quantitative standardization of polyphenols in Agrimoniae eupatoriae herba (Ph. Eur). J. Pharm. Biomed. Anal. 2013, 86, 112–122. [Google Scholar] [CrossRef] [PubMed]
- Granica, S.; Kluge, H.; Horn, G.; Matkowski, A.; Kiss, A.K. The phytochemical investigation of Agrimonia eupatoria L. and Agrimonia procera Wallr. as valid sources of Agrimoniae herba—The pharmacopoeial plant material. J. Pharm. Biomed. Anal. 2015, 114, 272–279. [Google Scholar] [CrossRef] [PubMed]
- Kuczmannova, A.; Gal, P.; Varinska, L.; Treml, J.; Kovac, I.; Novotny, M.; Vasilenko, T.; Dall’Acqua, S.; Nagy, M.; Mucaji, P. Agrimonia eupatoria L. and Cynara cardunculus L. water infusions: Phenolic profile and comparison of antioxidant activities. Molecules 2015, 20, 20538–20550. [Google Scholar] [CrossRef]
- Kubinova, R.; Svajdlenka, E.; Jankovska, D. Anticholinesterase, antioxidant activity and phytochemical investigation into aqueous extracts from five species of Agrimonia genus. Nat. Prod. Res. 2016, 30, 1174–1177. [Google Scholar] [CrossRef]
- Pukalskiene, M.; Slapsyte, G.; Dedonyte, V.; Lazutka, J.R.; Mierauskiene, J.; Venskutonis, P.R. Genotoxicity and antioxidant activity of five Agrimonia and Filipendula species plant extracts evaluated by comet and micronucleus assays in human lymphocytes and Ames Salmonella/microsome test. Food Chem. Toxicol. 2018, 113, 303–313. [Google Scholar] [CrossRef]
- Venskutonis, P.R.; Skemaite, M.; Sivik, B. Assessment of radical scavenging capacity of Agrimonia extracts isolated by supercritical carbon dioxide. J. Supercrit. Fluids 2008, 45, 231–237. [Google Scholar] [CrossRef]
- Bilia, A.R.; Palme, E.; Marsili, A.; Pistelli, L.; Morelli, I. A flavonol glycoside from Agrimonia eupatoria. Phytochemistry 1993, 32, 1078–1079. [Google Scholar] [CrossRef]
- Turker, A.U.; Yildirim, A.B.; Tas, I.; Ozkan, E.; Turker, H. Evaluation of some traditional medicinal plants: Phytochemical profile, antibacterial and antioxidant potentials. Rom. Biotechnol. Lett. 2021, 26, 2499–2510. [Google Scholar] [CrossRef]
- Huzio, N.; Grytsyk, A.; Raal, A.; Grytsyk, L.; Koshovyi, O. Phytochemical and pharmacological research in Agrimonia eupatoria L. herb extract with anti-inflammatory and hepatoprotective properties. Plants 2022, 11, 2371. [Google Scholar] [CrossRef]
- Patil, M.P.; Seo, Y.B.; Kim, G.D. Morphological changes of bacterial cells upon exposure of silver-silver chloride nanoparticles synthesized using Agrimonia pilosa. Microb. Pathog. 2018, 116, 84–90. [Google Scholar] [CrossRef]
- Balážová, Ľ.; Čižmárová, A.; Baláž, M.; Daneu, N.; Salayová, A.; Bedlovičová, Z.; Tkáčiková, Ľ. Green Synthesis of Silver Nanoparticles and Their Antibacterial Activity. Chem. Listy 2022, 116, 135–140. [Google Scholar] [CrossRef]
- Kováčová, M.; Daneu, N.; Tkáčiková, Ľ.; Dutkova, E.; Lukáčová Bujňáková, Z.; Baláž, M. Sustainable one-step solid-state synthesis of antibacterially active silver nanoparticles using mechanochemistry. Nanomaterials 2020, 10, 2119. [Google Scholar] [CrossRef]
- Mulvaney, P. Surface plasmon spectroscopy of nanosized metal particles. Langmuir 1996, 12, 788–800. [Google Scholar] [CrossRef]
- Yang, N.; Li, W.H. Mango peel extract mediated novel route for synthesis of silver nanoparticles and antibacterial application of silver nanoparticles loaded onto non-woven fabrics. Ind. Crops Prod. 2013, 48, 81–88. [Google Scholar] [CrossRef]
- Moopantakath, J.; Imchen, M.; Sreevalsan, A.; Siddhardha, B.; Martinez-Espinosa, R.M.; Kumavath, R. Biosynthesis of Silver Chloride Nanoparticles (AgCl-NPs) from Extreme Halophiles and Evaluation of Their Biological Applications. Curr. Microbiol. 2022, 79, 9. [Google Scholar] [CrossRef]
- Boonupara, T.; Kajitvichyanukul, P. Facile synthesis of plasmonic Ag/AgCl nanoparticles with aqueous garlic extract (Allium Sativum L.) for visible-light triggered antibacterial activity. Mater. Lett. 2020, 277, 128362. [Google Scholar] [CrossRef]
- Hassan, K.T.; Ibraheem, I.J.; Hassan, O.M.; Obaid, A.S.; Ali, H.H.; Salih, T.A.; Kadhim, M.S. Facile green synthesis of Ag/AgCl nanoparticles derived from Chara algae extract and evaluating their antibacterial activity and synergistic effect with antibiotics. J. Environ. Chem. Eng. 2021, 9, 4. [Google Scholar] [CrossRef]
- Royji Albeladi, S.S.; Malik, M.A.; Al-Thabaiti, S.A. Facile biofabrication of silver nanoparticles using Salvia officinalis leaf extract and its catalytic activity towards Congo red dye degradation. J. Mater. Res. Technol. 2020, 9, 10031–10044. [Google Scholar] [CrossRef]
- Szydłowska-Czerniak, A.; Tułodziecka, A.; Szłyk, E. A silver nanoparticle-based method for determination of antioxidant capacity of rapeseed and its products. Analyst 2012, 137, 3750–3759. [Google Scholar] [CrossRef]
- Liu, W.J.; Hou, X.Q.; Chen, H.; Liang, J.Y.; Sun, J.B. Chemical constituents from Agrimonia pilosa Ledeb. and their chemotaxonomic significance. Nat. Prod. Res. 2016, 30, 2495–2499. [Google Scholar] [CrossRef] [PubMed]
- Bhutto, A.A.; Kalay, Ş.; Sherazi, S.T.H.; Culha, M. Quantitative structure–activity relationship between antioxidant capacity of phenolic compounds and the plasmonic properties of silver nanoparticles. Talanta 2018, 189, 174–181. [Google Scholar] [CrossRef] [PubMed]
- Shabana, M.; Werglarz, Z.; Geszprych, A.; Mansour, R.; El-Ansaei, M. Phenolic constituents of agrimony (Agrimonia eupatoria L.) herb. Herba Pol. 2003, 49, 24–28. [Google Scholar]
- Lee, K.Y.; Hwang, L.; Jeong, E.J.; Kim, S.H.; Kim, Y.C.; Sung, S.H. Effect of Neuroprotective Flavonoids of Agrimonia eupatoria on Glutamate-Induced Oxidative Injury to HT22 Hippocampal Cells. Biosci. Biotechnol. Biochem. 2010, 74, 1704–1706. [Google Scholar] [CrossRef] [PubMed]
- Al-Snafi, A. The pharmacological and therapeutic importance of Agrimonia eupatoria—A review. Asian J. Pharm. Sci. Technol. 2015, 5, 112–117. [Google Scholar]
- Le Men, J.; Pourrat, H. Répartition de L’acide Ursolique dans les Feuilles de Diverses Rosacées; Acide Ursolique (Cinquième Mémoire); Travaux Des Laboratoires de Matière Médicale et de Pharmacie Galénique de La Faculté de Pharmacie de Paris la Cour d’Appel: Paris, France, 1955; p. 4. [Google Scholar]
- Giuliano, E.; Paolino, D.; Fresta, M.; Cosco, D. Mucosal Applications of Poloxamer 407-Based Hydrogels: An Overview. Pharmaceutics 2018, 10, 159. [Google Scholar] [CrossRef]
- Bain, M.K.; Bhowmick, B.; Maity, D.; Mondal, D.; Mollick, M.M.R.; Rana, D.; Chattopadhyay, D. Synergistic effect of salt mixture on the gelation temperature and morphology of methylcellulose hydrogel. Int. J. Biol. Macromol. 2012, 51, 831–836. [Google Scholar] [CrossRef]
- Boonrat, O.; Tantishaiyakul, V.; Hirun, N. Micellization and gelation characteristics of different blends of pluronic F127/methylcellulose and their use as mucoadhesive in situ gel for periodontitis. Polym. Bull. 2022, 79, 4515–4534. [Google Scholar] [CrossRef]
- Zhu, Z.L.; Zhai, Y.L.; Zhang, N.; Leng, D.L.; Ding, P.T. The development of polycarbophil as a bioadhesive material in pharmacy. Asian J. Pharm. Sci. 2013, 8, 218–227. [Google Scholar] [CrossRef]
- Kulkarni, A.S.; Dhanwe, V.P.; Dhumure, A.B.; Khan, A.; Shinde, V.S.; Khanna, P.K. In situ formation of silver nanoparticles in thermosensitive glycogels and evaluation of its antibacterial activity. Indian J. Chem. Sect. A-Inorg. Bio-Inorg. Phys. Theor. Anal. Chem. 2016, 55, 441–446. [Google Scholar]
- Edison, T.J.I.; Sethuraman, M.G. Instant green synthesis of silver nanoparticles using Terminalia chebula fruit extract and evaluation of their catalytic activity on reduction of methylene blue. Process Biochem. 2012, 47, 1351–1357. [Google Scholar] [CrossRef]
- Sathishkumar, M.; Rajamanickam, A.T.; Saroja, M. Characterization, antimicrobial activity and photocatalytic degradation properties of pure and biosynthesized zinc sulfide nanoparticles using plant extracts. J. Mater. Sci. Mater. Electron. 2018, 29, 14200–14209. [Google Scholar] [CrossRef]
- Izak-Nau, E.; Huk, A.; Reidy, B.; Uggerud, H.; Vadset, M.; Eiden, S.; Voetz, M.; Himly, M.; Duschl, A.; Dusinska, M.; et al. Impact of storage conditions and storage time on silver nanoparticles’ physicochemical properties and implications for their biological effects. Rsc. Adv. 2015, 5, 84172–84185. [Google Scholar] [CrossRef]
- Velgosova, O.; Cizmarova, E.; Malek, J.; Kavulicova, J. Effect of storage conditions on long-term stability of Ag nanoparticles formed via green synthesis. Int. J. Miner. Metall. Mater. 2017, 24, 1177–1182. [Google Scholar] [CrossRef]
- Wang, Y.C.; Zheng, Y.; Zhang, L.; Wang, Q.W.; Zhang, D.R. Stability of nanosuspensions in drug delivery. J. Control. Release 2013, 172, 1126–1141. [Google Scholar] [CrossRef]
- Alcantara, M.T.S.; Lincopan, N.; Santos, P.M.; Ramirez, P.A.; Brant, A.J.C.; Riella, H.G.; Lugao, A.B. Simultaneous hydrogel crosslinking and silver nanoparticle formation by using ionizing radiation to obtain antimicrobial hydrogels. Radiat. Phys. Chem. 2020, 169, 108777. [Google Scholar] [CrossRef]
- Mock, J.J.; Barbic, M.; Smith, D.R.; Schultz, D.A.; Schultz, S. Shape effects in plasmon resonance of individual colloidal silver nanoparticles. J. Chem. Phys. 2002, 116, 6755–6759. [Google Scholar] [CrossRef]
- Muruzovic, M.Z.; Mladenovic, K.G.; Stefanovic, O.D.; Vasic, S.M.; Comic, L.R. Extracts of Agrimonia eupatoria L. as sources of biologically active compounds and evaluation of their antioxidant, antimicrobial, and antibiofilm activities. J. Food Drug Anal. 2016, 24, 539–547. [Google Scholar] [CrossRef]
- Watkins, F.; Pendry, B.; Sanchez-Medina, A.; Corcoran, O. Antimicrobial assays of three native British plants used in Anglo-Saxon medicine for wound healing formulations in 10th century England. J. Ethnopharmacol. 2012, 144, 408–415. [Google Scholar] [CrossRef]
- Cardoso, O.; Donato, M.M.; Luxo, C.; Almeida, N.; Liberal, J.; Figueirinha, A.; Batista, M.T. Anti-Helicobacter pylori potential of Agrimonia eupatoria L. and Fragaria vesca. J. Funct. Foods 2018, 44, 299–303. [Google Scholar] [CrossRef]
- Cwikla, C.; Schmidt, K.; Matthias, A.; Bone, K.M.; Lehmann, R.; Tiralongo, E. Investigations into the Antibacterial Activities of Phytotherapeutics against Helicobacter pylori and Campylobacter jejuni. Phytother. Res. 2010, 24, 649–656. [Google Scholar] [CrossRef] [PubMed]
- Komiazyk, M.; Palczewska, M.; Sitkiewicz, I.; Pikula, S.; Groves, P. Neutralization of cholera toxin by Rosaceae family plant extracts. BMC Complement. Altern. Med. 2019, 19, 140. [Google Scholar] [CrossRef] [PubMed]
- Shaaban, M.T.; Zayed, M.; Salama, H.S. Antibacterial Potential of Bacterial Cellulose Impregnated with Green Synthesized Silver Nanoparticle Against, S. aureus and P. aeruginosa. Curr. Microbiol. 2023, 80, 2. [Google Scholar] [CrossRef] [PubMed]
- Vijayakumar, G.; Kim, H.J.; Rangarajulu, S.K. In Vitro Antibacterial and Wound Healing Activities Evoked by Silver Nanoparticles Synthesized through Probiotic Bacteria. Antibiotics 2023, 12, 141. [Google Scholar] [CrossRef]
- Pal, S.; Tak, Y.K.; Song, J.M. Does the antibacterial activity of silver nanoparticles depend on the shape of the nanoparticle? A study of the gram-negative bacterium Escherichia coli. Appl. Environ. Microbiol. 2007, 73, 1712–1720. [Google Scholar] [CrossRef]
- Salayová, A.; Bedlovičová, Z.; Daneu, N.; Bujňáková, Z.; Balážová, Ľ.; Tkáčiková, Ľ.; Baláž, M. Green synthesis of silver nanoparticles with antibacterial activity using various medicinal plant extracts: Morphology and an-tibacterial efficacy. Nanomaterials 2021, 11, 1005. [Google Scholar] [CrossRef]

| Compound | Rt (Min) | UV Max (nm) | Calibration Range (mg·L−1) | Regression | Concentration (mg·L−1) | ||
|---|---|---|---|---|---|---|---|
| Slope | Offset | R2 | |||||
| Gallic acid | 3.87 | 214, 274 | 0.01–20 | 0.1740 | −0.0603 | 0.9994 | 0.83 |
| Chlorogenic acid | 7.72 | 248, 328 | 0.01–20 | 0.1581 | −0.0048 | 0.995 | 1.03 |
| Caffeic acid | 9.11 | 245, 326 | 0.01–20 | 0.2738 | −0.0671 | 0.995 | 1.39 |
| p-Coumaric acid | 11.40 | 309 | 0.01–20 | 0.3341 | −0.0603 | 0.9988 | 3.83 |
| o-Coumaric acid | 13.35 | 279, 327 | 0.01–20 | 0.1504 | −0.0268 | 0.9987 | 3.06 |
| Rutin trihydrate | 14.23 | 260, 357 | 0.01–20 | 0.0722 | −0.0221 | 0.9991 | 6.56 |
| Rosmarinic acid | 14.54 | 250, 331 | 0.01–20 | 0.1513 | −0.0367 | 0.9991 | N.D. |
| Cinnamic acid | 15.39 | 280 | 0.01–20 | 0.4832 | −0.0886 | 0.9986 | 0.33 |
| Quercetin | 18.60 | 259, 374 | 0.05–20 | 0.1454 | −0.1157 | 0.9968 | N.D. |
| ν(O-H) | ν(C-H) | ν(C-H) | ν(C=O) | ν(C=C) ν(C=O) δ(N-H) | δ(C-OH) Phenol | δ(CCH) δ(CH3) ν(−C−O−C) ν(C–O) Alcohol ν(C–N) ν(C–C) | |
|---|---|---|---|---|---|---|---|
| Agrimonia eupatoria L. | 3222 | 2916 | 2848 | 1602 | 1396 | 1246–1043 | |
| supernantant after AgNP synthesis | 3222 | 2914 | 2846 | 1720 | 1604 | 1371 | 1236–1039 |
| Ag NPs | 3224 | 2914 | 2846 | 1637, 1514, 1456 |
Disclaimer/Publisher’s Note: The statements, opinions and data contained in all publications are solely those of the individual author(s) and contributor(s) and not of MDPI and/or the editor(s). MDPI and/or the editor(s) disclaim responsibility for any injury to people or property resulting from any ideas, methods, instructions or products referred to in the content. |
© 2023 by the authors. Licensee MDPI, Basel, Switzerland. This article is an open access article distributed under the terms and conditions of the Creative Commons Attribution (CC BY) license (https://creativecommons.org/licenses/by/4.0/).
Share and Cite
Balážová, Ľ.; Wolaschka, T.; Rohaľová, S.; Daneu, N.; Stahorský, M.; Salayová, A.; Tkáčiková, Ľ.; Eftimová, J. In Situ Gel with Silver Nanoparticles Prepared Using Agrimonia eupatoria L. Shows Antibacterial Activity. Life 2023, 13, 573. https://doi.org/10.3390/life13020573
Balážová Ľ, Wolaschka T, Rohaľová S, Daneu N, Stahorský M, Salayová A, Tkáčiková Ľ, Eftimová J. In Situ Gel with Silver Nanoparticles Prepared Using Agrimonia eupatoria L. Shows Antibacterial Activity. Life. 2023; 13(2):573. https://doi.org/10.3390/life13020573
Chicago/Turabian StyleBalážová, Ľudmila, Tomáš Wolaschka, Simona Rohaľová, Nina Daneu, Martin Stahorský, Aneta Salayová, Ľudmila Tkáčiková, and Jarmila Eftimová. 2023. "In Situ Gel with Silver Nanoparticles Prepared Using Agrimonia eupatoria L. Shows Antibacterial Activity" Life 13, no. 2: 573. https://doi.org/10.3390/life13020573
APA StyleBalážová, Ľ., Wolaschka, T., Rohaľová, S., Daneu, N., Stahorský, M., Salayová, A., Tkáčiková, Ľ., & Eftimová, J. (2023). In Situ Gel with Silver Nanoparticles Prepared Using Agrimonia eupatoria L. Shows Antibacterial Activity. Life, 13(2), 573. https://doi.org/10.3390/life13020573

